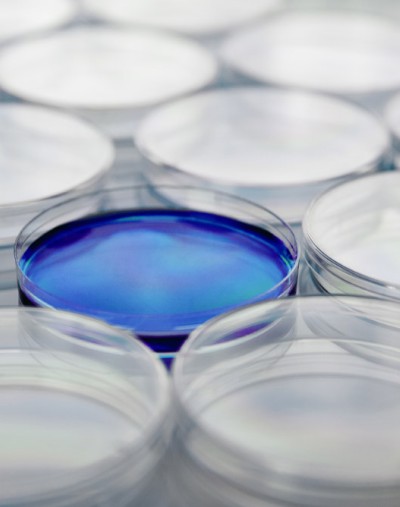

Life Sciences
We are committed to driving innovation in pharmaceuticals and medical devices through rigorous research, diagnostics, and expert regulatory support
Our Life Science division specializes in clinical studies, design development, quality assurance, data management, eCRF solutions, medical writing, and quality control samples. With a deep understanding of industry requirements, we serve pharmaceutical companies, CROs, medical manufacturers, and the scientific community, ensuring compliance with global standards.
Our expertise is grounded in international regulatory frameworks, including EU, FDA, and ICH guidelines, as well as national authorities such as ANVISA, TGA, and PMDA.
The best of the best:
our expertise
With our expertise, we check that your products and services comply with international standards.
CERTANIA is your reliable partner for testing, inspection, certification and compliance
Our Life Sciences service segment specializes in research across pharmaceuticals, medical devices, and health diagnostics. The CERTANIA Group rigorously adheres to scientific best practices, consistently meeting international standards and regulatory requirements.
ClinicalResearch
Clinical research from early development to approval: clinical studies phase I-IV, data management, biometrics, pharmacokinetics and regulatory compliant IT and data solutions for reliable study results.
Learn moreHealthcareServices
Pharmaceutical analysis, hygiene and quality management as well as laboratory diagnostics: stability tests, GMP-compliant tests, audits and quality control materials for safe, effective and reliable healthcare products.
Learn moreMedTech
Testing, engineering and consulting services for medical and pharmaceutical products: Laboratory, biocompatibility and implant testing, validation and regulatory support for safe, international approvals.
Learn more